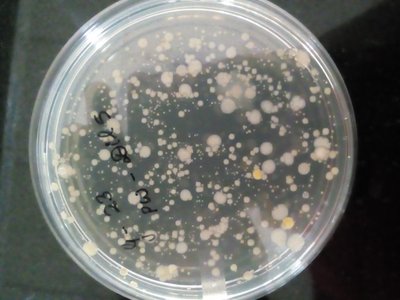
featured

utpal-biswas (43)
Biologist & Wildlife Photographer
10 followers10 postsNot following anybody25 HP
Blacklisted UsersMuted UsersFollowed BlacklistsFollowed Muted Lists
Blacklisted UsersMuted UsersFollowed BlacklistsFollowed Muted Lists
India steemit.com/@utpal-biswas Joined July 2019 Active 6 years ago